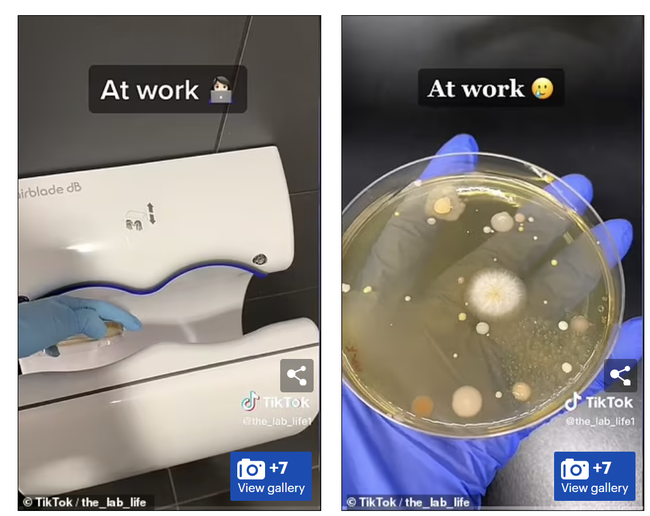
Th&iacute; nghiệm g&acirc;y sốc cho thấy điều xảy ra với 1 thiết bị quen thuộc trong toilet: Chuy&ecirc;n gia cảnh b&aacute;o ngừng sử dụng - Ảnh 1.
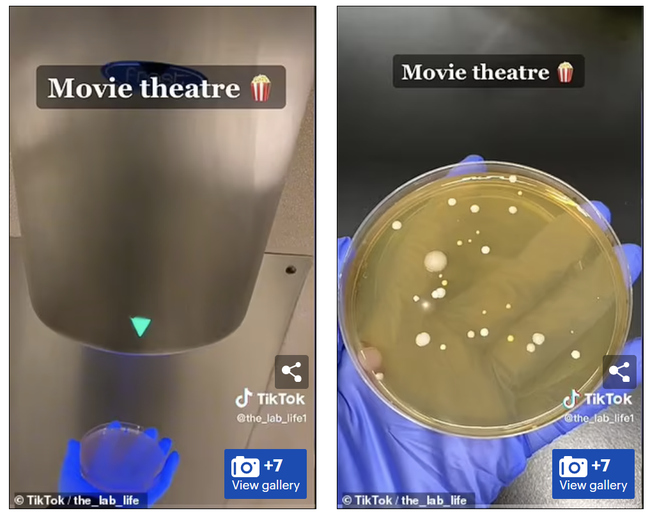
Th&iacute; nghiệm g&acirc;y sốc cho thấy điều xảy ra với 1 thiết bị quen thuộc trong toilet: Chuy&ecirc;n gia cảnh b&aacute;o ngừng sử dụng - Ảnh 2.

Thí nghiệm gây sốc cho thấy điều xảy ra với 1 thiết bị quen thuộc trong toilet: Chuyên gia cảnh báo ngừng sử dụng
Phát hiện mới đã khiến nhiều người phải suy nghĩ lại trước khi sử dụng thiết bị này trong nhà vệ sinh.
- Tan chảy trong bàn tay, thứ kim loại hiếm có trong tự nhiên này nắm giữ "trái tim" xe điện, Mỹ ráo riết tìm nhà bán
- CEO Taxi "Phạm Nhật Vượng" tiết lộ con số khủng ngày chính thức ra mắt: Dự án nghìn tỷ làm trong 38 ngày, năm nay chạy 10.000 xe
- Taxi điện cao cấp VF8: Tài xế mặc vest như doanh nhân, trải nghiệm dịch vụ '"sang chảnh" chẳng khác nào chủ tịch
Máy sấy tay ẩn chứa một bí mật kinh khủng, nó đích thực là máy hút vi khuẩn từ không khí và sau đó "xịt" vi khuẩn lên bàn tay mới rửa của chúng ta.
Theo tờ Daily Mail (Anh), những vi khuẩn vô hình này vừa được phát hiện bởi một Tiktoker có tên tài khoản là @the_lab_life1, một nữ sinh viên chuyên ngành khoa học. Kênh TikTok the_lab_life1 hiện gần 400.000 lượt người theo dõi với nội dung chủ yếu là những video thử nghiệm do cô nàng thực hiện.
@the_lab_life1 gần đây đã lấy mẫu từ máy sấy trong trung tâm mua sắm, rạp chiếu phim và tại nơi sinh hoạt - làm việc để tiến hành thí nghiệm, cuối cùng thu được kết quả đáng lo ngại như trên.
Sau khi đăng tải, đoạn video gây sốc của @the_lab_life1 đã thu hút hơn 2 triệu lượt thích và hơn 12.000 bình luận từ cộng đồng mạng, phần lớn đều cảm thấy kinh hoàng trước phát hiện này. Kết quả thu được khiến nhiều người phải suy nghĩ lại về việc sử dụng máy sấy tay trong nhà vệ sinh, thay vì sử dụng khăn giấy do nghĩ cách đó sạch sẽ hơn.
Mẫu lấy từ nơi làm việc.
"Tôi luôn thắc mắc mỗi lần dùng máy sấy tay" – Một người dùng bình luận.
Trong khi đó, một người khác chia sẻ: "Đây là lý do tại sao tôi để nguyên tay ướt khi bước ra khỏi phòng tắm. Các bạn sẽ không bắt gặp tôi dùng máy sấy tay bao giờ".
TikToker the_lab_life1 giải thích rằng, máy sấy tay không phải là loại máy chứa đầy vi khuẩn, mà nó đẩy vi khuẩn có mặt trong nhà vệ sinh lên bàn tay của bạn.
Mặc dù cô không tiết lộ loại vi khuẩn mà mình tìm thấy nhưng theo Daily Mail, các nghiên cứu trước đây đã cho thấy có vi khuẩn E. Coli (gây các bệnh về đường tiêu hóa), vi khuẩn coliform (có trong phân của người), liên cầu khuẩn… trong nhà vệ sinh công cộng.
Mẫu lấy từ rạp chiếu phim.
Một nghiên cứu năm 2015 đã phát hiện thấy dấu vết của hơn 77.000 loại vi khuẩn và virus khác nhau trong không gian sinh hoạt này. Khi bạn sử dụng máy sấy tay, lực sấy mạnh sẽ khiến những vi khuẩn có trong nhà vệ sinh công cộng bị nhấc khỏi bề mặt và đẩy chúng lên tay của bạn.
Nghiên cứu do Đại học Connecticut và Đại học Quinnipiac thực hiện vào năm 2018 cho thấy, khi đặt các đĩa Petri chứa "thức ăn của vi khuẩn" trong phòng tắm không có máy sấy tay, nhóm phân tích chỉ tìm thấy 6 khuẩn lạc mầm bệnh phát triển trong vòng 18 giờ. Tuy nhiên, trong điều kiện có máy sấy tay, con số này lên tới 254 chỉ trong 30 giây chiếc máy hoạt động.
Trong số vi khuẩn tìm thấy có Staphylococcus aureus, một loại vi khuẩn tụ cầu có độc tính cao, có thể kháng với nhiều loại kháng sinh. Đây là loại vi khuẩn có thể gây nhiễm trùng huyết, viêm phổi hoặc gây ra hội chứng sốc nhiễm độc.

Mẫu lấy từ trung tâm mua sắm.
Mặc dù hội chứng sốc nhiễm khuẩn rất hiếm gặp nhưng nó có tính đột ngột, dễ gây nguy hiểm cho người bệnh khi vi khuẩn tụ cầu vàng phát triển quá mức và giải phóng độc tố. Người bệnh thường xuất hiện các triệu chứng như: hôn mê, thở nhanh nông có thể có những cơn ngừng thở, mạch nhanh nhỏ và khó bắt, huyết áp tụt, chân tay lạnh, tiểu ít hoặc vô niệu,...
Bên cạnh đó, theo các nhà khoa học, máy sấy tay còn có khả năng làm lây lan vi khuẩn Clostridium difficile gây tiêu chảy, có thể khiến cơ thể mất nước nghiêm trọng.
"Điều này cho thấy một phương thức lây truyền Clostridium difficile mới, đáng nói, phương thức này có thể sẽ không bị gián đoạn bởi cách rửa tay hoặc các phương pháp khử nhiễm bề mặt truyền thống" – Nghiên cứu công bố trên tạp chí AMS cho hay.
Với những phát hiện đó, theo Daily Mail, các chuyên gia khuyến cáo mọi người hãy sử dụng khăn giấy để lau khô tay.
Theo Tiến sĩ Keith Redway, trưởng nhóm nghiên cứu thuộc Đại học Westminster, khăn giấy dùng một lần ít lây lan vi khuẩn nhất trong tất cả các phương pháp làm khô tay.
-

Lừa đảo "Cún cưng săn mồi": Nhiều người mất tiền oan chỉ sau vài giây ngắm 1 bức ảnh, Google phát cảnh báo khẩn
-

Người giàu cũng khóc: iPhone 15 lộ giá bán cao đến khó tin, phiên bản Pro Max gần 70 triệu đồng?
-

Một loại "bút thần" từng gây sốt ở Việt Nam có thể khiến tài sản lớn bay hơi: Nhiều nước đau đầu vì "ma thuật kỳ ảo"
